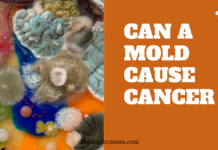
Can Mold Cause Cancer: Separating Fact from Fiction Can Mold Cause Cancer

Buttock Pain Cancer Symptoms : Is Your Buttock Pain Cancer
Pain In The Buttocks: Is It A Symptom Of Cancer?
Pain in the buttocks can be alarming and disruptive to daily life. While it’s often caused by benign conditions, persistent or severe buttock pain can sometimes be a symptom of cancer. Understanding the potential causes, symptoms, and treatments can help in identifying serious health issues early on.
Is Your Buttock Pain Cancer?
Buttock pain can stem from various causes, including muscle strain, sciatica, bursitis, and, in rare cases, cancer. It’s crucial to differentiate between common, non-cancerous conditions and more serious oncological causes. Read about Is Heel Pain a Sign of Cancer
Can Cancer Cause Lower Back Pain?
Yes, cancer can cause lower back pain. Cancers such as bone metastases, soft tissue sarcomas, and cancers of the rectum, prostate, and gynecological regions can spread to or originate near the buttocks and lower back, causing pain.
Is Your Buttock Pain Cancer? Cancer Specialist Explains
According to cancer specialists, buttock pain related to cancer is usually accompanied by other symptoms such as unexplained weight loss, changes in bowel habits, and persistent pain that doesn’t improve with rest or over-the-counter medications. Early diagnosis is crucial for effective treatment. Also read the Article: Is Low Potassium a Sign of Cancer
Causes of Buttock Pain and Treatment Options

Common Causes
- Bruising: Often caused by trauma or injury, resulting in a swollen lump and tenderness.
- Muscle Strain: Overexertion or improper lifting techniques can lead to muscle strains, causing swelling, stiffness, and trouble moving.
- Sciatica: Compression or irritation of the sciatic nerve can cause sharp or burning pain radiating from the lower back through the buttocks and down the leg.
- Bursitis: Inflammation of the bursae, fluid-filled sacs that cushion bones, can cause pain, especially when sitting or lying down.
- Herniated Disc: Discs that cushion the spine can tear, pressing on nerves and causing pain.
- Degenerative Disc Disease: Discs wear down with age, causing pain in the lower back and buttocks.
- Piriformis Syndrome: Inflammation of the piriformis muscle can compress the sciatic nerve, causing pain.
- Pilonidal Cyst: A cyst containing hair and skin debris can form near the buttocks, causing pain and infection.
- Perirectal Abscess: An infection near the anus can cause a pus-filled cavity, leading to pain.
- Sacroiliac Joint Dysfunction: Inflammation of the sacroiliac joint can cause pain that radiates from the lower back to the buttocks.
Cancer-Related Causes
- Bone Cancer: Metastatic bone cancer can cause deep, aching pain in the buttocks.
- Soft Tissue Sarcomas: These rare cancers can develop in the muscles of the buttocks, causing pain, swelling, or a lump.
- Rectal Cancer: Can cause pain during bowel movements, changes in bowel habits, and blood in the stool.
- Prostate Cancer: Can spread to bones in the pelvic region, causing buttock pain, urinary problems, and erectile dysfunction.
- Gynecological Cancers: Cancers of the ovaries, cervix, or uterus can cause referred pain to the buttocks or pelvic area.
Buttock Pain Cancer Symptoms and Diagnosis
Symptoms to Watch For
- Persistent Pain: Pain that doesn’t improve with rest or medication.
- Changes in Bowel Habits: Blood in the stool, persistent diarrhea, or constipation.
- Unexplained Weight Loss: Rapid, unintentional weight loss.
- Lumps or Swelling: Notable lumps in the buttock or pelvic area.
- Urinary Problems: Difficulty urinating or erectile dysfunction in men.
Diagnostic Procedures
- Imaging Tests: X-rays, MRI scans, or CT scans can identify abnormalities or tumors.
- Biopsy: Tissue sample collection to confirm the presence of cancer cells.
- Blood Tests: To check for markers indicative of cancer.
What Causes Buttock Muscle Pain and How to Relieve It

Non-Cancerous Causes
- Muscular Strain: Often due to overuse or improper movements. Relief can come from rest, ice, compression, and elevation (RICE method).
- Sciatica: Stretches and exercises can help relieve sciatic nerve pain.
- Herniated Disc: Physical therapy and anti-inflammatory medications can aid recovery.
Relief Methods
- Physical Therapy: Strengthening and flexibility exercises.
- Medication: Pain relievers, anti-inflammatories, or muscle relaxants.
- Surgery: In severe cases, to repair herniated discs or remove cysts.
Cancer-related Buttock Pain
Cancer can cause buttock pain by spreading to nearby bones, muscles, or nerves. Tumors can exert pressure on these structures, leading to discomfort and other symptoms.
Buttock Pain Tumor Symptoms
- Deep, Constant Pain: Often worsening at night or with movement.
- Swelling or Lump: Notable mass in the buttock area.
- Radiating Pain: Pain spreading to the legs or lower back.
Symptoms of Cancer in the Buttock Area
- Persistent Discomfort: Pain that doesn’t subside with conventional treatments.
- Lump or Mass: Unusual growth in the buttocks.
- Unexplained Weight Loss: Along with buttock pain.
- Changes in Bowel or Bladder Habits: Difficulty or changes in urination and defecation.
Oncological Causes of Buttock Pain
- Bone Metastases: Cancer spreading to the bones in the buttock region.
- Soft Tissue Sarcomas: Rare cancers developing in buttock muscles.
- Colorectal and Rectal Cancer: Can cause referred pain to the buttocks.
Signs of Cancer Causing Buttock Pain
- Persistent, Deep Pain: Not relieved by rest or medication.
- Changes in Bowel Habits: Blood in stool or persistent changes.
- Unexplained Symptoms: Weight loss, lumps, or urinary issues.
Buttock Discomfort and Cancer Indicators
- Continuous Pain: Not improving with typical treatments.
- New Lumps or Swelling: Particularly in the buttocks or pelvic area.
- Associated Symptoms: Weight loss, bowel changes, urinary problems.
Cancer Symptoms Associated with Buttock Pain
- Constant Pain: Persistent discomfort despite rest.
- Systemic Symptoms: Weight loss, fatigue, fever.
- Local Symptoms: Lumps, swelling, changes in bowel or urinary habits.
Buttock Pain Linked to Cancer
Persistent buttock pain linked to cancer is often accompanied by other warning signs. Identifying these early can lead to a better prognosis.
Identifying Cancer from Buttock Pain
Early identification involves recognizing persistent pain, changes in bowel habits, and unexplained weight loss. Diagnostic tests like imaging and biopsies can confirm the presence of cancer.
Medical Signs of Buttock Pain Cancer
- Persistent, Non-Relieving Pain: Deep pain not improving with rest.
- Notable Lumps or Swelling: New growths in the buttocks or pelvic area.
- Associated Symptoms: Weight loss, bowel or urinary changes.
Conclusion
While buttock pain is often due to benign causes like muscle strain or sciatica, it can sometimes be a symptom of cancer. Recognizing the signs early and seeking prompt medical attention can improve outcomes. If you experience persistent or severe buttock pain, consult a healthcare professional for a thorough evaluation to rule out any underlying health issues.
FAQs
Can buttock pain be the only symptom of cancer? No, buttock pain is rarely the sole symptom of cancer. It is usually accompanied by other concerning signs, such as changes in bowel habits or unexplained weight loss.
Is buttock pain associated with a specific type of cancer? Buttock pain can be linked to various types of cancer, including bone cancer, colorectal cancer, and soft tissue sarcomas. However, it is not exclusive to any particular type.
What should I do if I have persistent buttock pain? If you have persistent buttock pain that does not improve with rest or over-the-counter medications, consult a healthcare professional for a thorough evaluation.
Can imaging tests detect cancer in the buttock area? Yes, imaging tests such as X-rays, MRI scans, or CT scans can help identify abnormalities or tumors in the buttock region and aid in the diagnosis of cancer.
How is buttock pain caused by cancer treated? Treatment for buttock pain caused by cancer depends on the type and stage of cancer. It may include surgery, chemotherapy, or radiation therapy, as recommended by your healthcare provider.